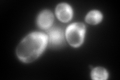
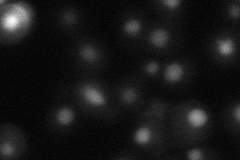
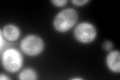

View description
Ribosomal stalk protein P1 alpha, involved in the interaction between translational elongation factors and the ribosome; accumulation of P1 in the cytoplasm is regulated by phosphorylation and interaction with the P2 stalk component
Localization:
Intensity:
Fold change:
Significance:
-
C’ GFP library in SD
cytosol791.06 -
N' NOP1pr-GFP in SD

nucleus36.1943 -
N' TEF2pr-mCherry in SD
nucleus328.18 -
N' NATIVEpr-GFP in SD

nucleus21.3241 -
N' TEF2pr-VC and Cyto-VN in SD

nucleus28.6898 -
C’ GFP library in SD+DTT
cytosol668.140.84No -
C’ GFP library in SD+H2O2

cytosol1025.071.29No -
C’ GFP library in Starvation Media

cytosol783.950.99No -
C’ GFP library on the background of Pup2-DaMP

cytosol -
C’ GFP library on the background of CCT mutant

cytosol701.9580.887356No
